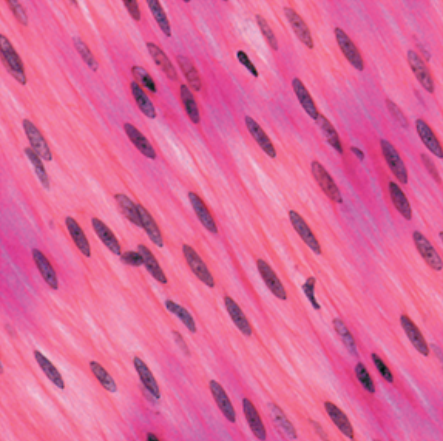
knowt flashcard image

1/219
Looks like no tags are added yet.
Name | Mastery | Learn | Test | Matching | Spaced | Call with Kai |
|---|
No analytics yet
Send a link to your students to track their progress
skeletal muscle tissue

smooth muscle tissue
cardiac muscle tissue

Intercalated disks
how are cardiac muscle tissue cells connected
Frontalis; facial nerve CN VII
ID muscle and innervation

Occipitalis; facial nerve CN VII
ID muscle and innervation

Galea aponeurotica (fascia)

Corrugator supercilii; facial nerve CN VII
ID muscle and innervation

Orbicularis oculi; facial nerve CN VII
ID muscle and innervation

Nasalis; facial nerve CN VII
ID muscle and innervation

Orbicularis oris; facial nerve CN VII
ID muscle and innervation

Levator labii superioris; facial nerve CN VII
ID muscle and innervation

Zygomaticus major; facial nerve CN VII
ID muscle and innervation

Zygomaticus minor; facial nerve CN VII
ID muscle and innervation

Risorius; facial nerve CN VII
ID muscle and innervation

Buccinator; facial nerve CN VII
ID muscle and innervation

Depressor anguli oris; facial nerve CN VII
ID muscle and innervation

Depressor labii inferioris; facial nerve CN VII
ID muscle and innervation

Mentalis; facial nerve CN VII
ID muscle and innervation

Platysma; facial nerve CN VII
ID muscle and innervation

Masseter; mandibular branch of the trigeminal nerve CN V
ID muscle and innervation

Temporalis; mandibular branch of the trigeminal nerve CN V
ID muscle and innervation

Medial pterygoid; mandibular branch of the trigeminal nerve CN V
ID muscle and innervation

Lateral pterygoid; mandibular branch of the trigeminal nerve CN V
ID muscle and innervation

Digastric; anterior belly: mandibular branch of the trigeminal nerve CN V, posterior belly: facial nerve CN VII
ID muscle and innervation

Stylohyoid; facial nerve CN VII
ID muscle and innervation

Geniohyoid; spinal nerve C1
ID muscle and innervation

Mylohyoid; mandibular branch of the trigeminal nerve CN V
ID muscle and innervation

Omohyoid; spinal nerves C1 - C3 & ansa cervicalis
ID muscle and innervation

Sternohyoid; spinal nerves C1 - C3 & ansa cervicalis
ID muscle and innervation

Sternothyroid; spinal nerves C1 - C3 & ansa cervicalis
ID muscle and innervation

Thyrohyoid; cervical spinal nerves C1 & C2 via hypoglossal nerve CN XII
ID muscle and innervation

Sternocleidomastoid (sternal and clavicular heads); accessory nerve CN XI & cervical spinal nerves C2 & C3
ID muscle and innervation

Cricothyroid; vagus nerve CN X
ID muscle and innervation

External oblique

Internal oblique

Transversus abdominus

Rectus abdominus

Linea alba

Rectus sheath

Tendinous intersections

Pectoralis major (sternocostal and clavicular head); medial and lateral pectoral nerves
ID muscle and innervation

Deltoid; axillary nerve
ID muscle and innervation

Coracobrachialis; musculocutaneous nerve
ID muscle and innervation (green)

Serratus anterior; long thoracic nerve
ID muscle and innervation

Pectoralis minor; medial and lateral pectoral nerve
ID muscle and innervation

Biceps brachii (long and short heads); musculocutaneous nerve
ID muscle and innervation (red)

Brachialis; musculocutaneous nerve
ID muscle and innervation (blue)

Brachioradialis; radial nerve
ID muscle and innervation (lateral orange)

Extensor carpi radialis longus; radial nerve
ID muscle and innervation (dark purple)

Extensor carpi radialis brevis; radial nerve
ID muscle and innervation (light blue)

Abductor pollicis longus; radial nerve
ID muscle and innervation (red)

Extensor pollicis brevis; radial nerve
ID muscle and innervation (purple)

Extensor pollicis longus; radial nerve
ID muscle and innervation (orange)

Extensor indicis; radial nerve
ID muscle and innervation (blue)

Extensor digitorum; radial nerve
ID muscle and innervation (yellow)

Extensor digiti minimi; radial nerve
ID muscle and innervation (green)

Extensor carpi ulnaris; radial nerve
ID muscle and innervation (light purple)

Extensor retinaculum (fascia)

Supinator; radial nerve
ID muscle and innervation (yellow)

Pronator teres; median nerve
ID muscle and innervation (yellow)

Pronator quadratus; median nerve
ID muscle and innervation (green)

Iliacus; femoral nerve (L2 & L3)
ID muscle and innervation (green)

Psoas major; ventral rami L1 - L3
ID muscle and innervation (teal)

Sartorius; femoral nerve (L2 & L3)
ID muscle and innervation (purple)

Rectus femoris; femoral nerve
ID muscle and innervation (yellow)

Vastus lateralis; femoral nerve
ID muscle and innervation (blue)

Vastus medialis; femoral nerve
ID muscle and innervation (red)

Vastus intermedius; femoral nerve
ID muscle and innervation

Patellar ligament

Tensor fasciae latae; superior gluteal nerve
ID muscle and innervation (yellow)

Iliotibial tract
ID (green)

Pectineus; femoral nerve (L2 & L3) & sometimes obturator nerve
ID muscle and innervation (orange)

Gracilis; obturator nerve (L2 & L3)
ID muscle and innervation

Adductor longus; obturator nerve
ID muscle and innervation (yellow)

Adductor magnus; obturator nerve & tibial division of the sciatic nerve
ID muscle and innervation (pink)

Tibialis anterior; deep peroneal nerve
ID muscle and innervation (green)

Extensor hallucis longus; deep peroneal nerve
ID muscle and innervation (purple)

Extensor digitorum longus; deep peroneal nerve
ID muscle and innervation (pink)

Peroneus tertius; deep peroneal nerve
ID muscle and innervation

Extensor retinaculum (fascia; superior and inferior)

Peroneus longus; superficial peroneal nerve
ID muscle and innervation (navy)

Peroneus brevis; superficial peroneal nerve
ID muscle and innervation (yellow)

Peroneal retinaculum (fascia)

Splenius capitis and cervicis; cervical spinal nerves
ID muscle and innervation (orange and yellow)

Erector spinae

Trapezius; accessory nerve CN XI & spinal nerves C3 & C4
ID muscle and innervation (orange)

Levator scapulae; spinal nerves C3 - C5
ID muscle and innervation (green)

Rhomboideus major; dorsal scapular nerve
ID muscle and innervation (light blue)

Rhomboideus minor; dorsal scapular nerve
ID muscle and innervation (dark blue)

Teres major; lower subscapular nerve
ID muscle and innervation (yellow)

Latissimus dorsi; thoracodorsal nerve
ID muscle and innervation (yellow)

Supraspinatus; suprascapular nerve
ID muscle and innervation (red)

Infraspinatus; suprascapular nerve
ID muscle and innervation (blue)

Subscapularis; subscapular nerve
ID muscle and innervation (green)

Teres minor; axillary nerve
ID muscle and innervation (yellow)

Triceps brachii (long, lateral, and medial heads); radial nerve
ID muscle and innervation

Anconeus; radial nerve
ID muscle and innervation (medial orange)

Flexor carpi radialis; median nerve
ID muscle and innervation (green)

Palmaris longus; median nerve
ID muscle and innervation (blue)
